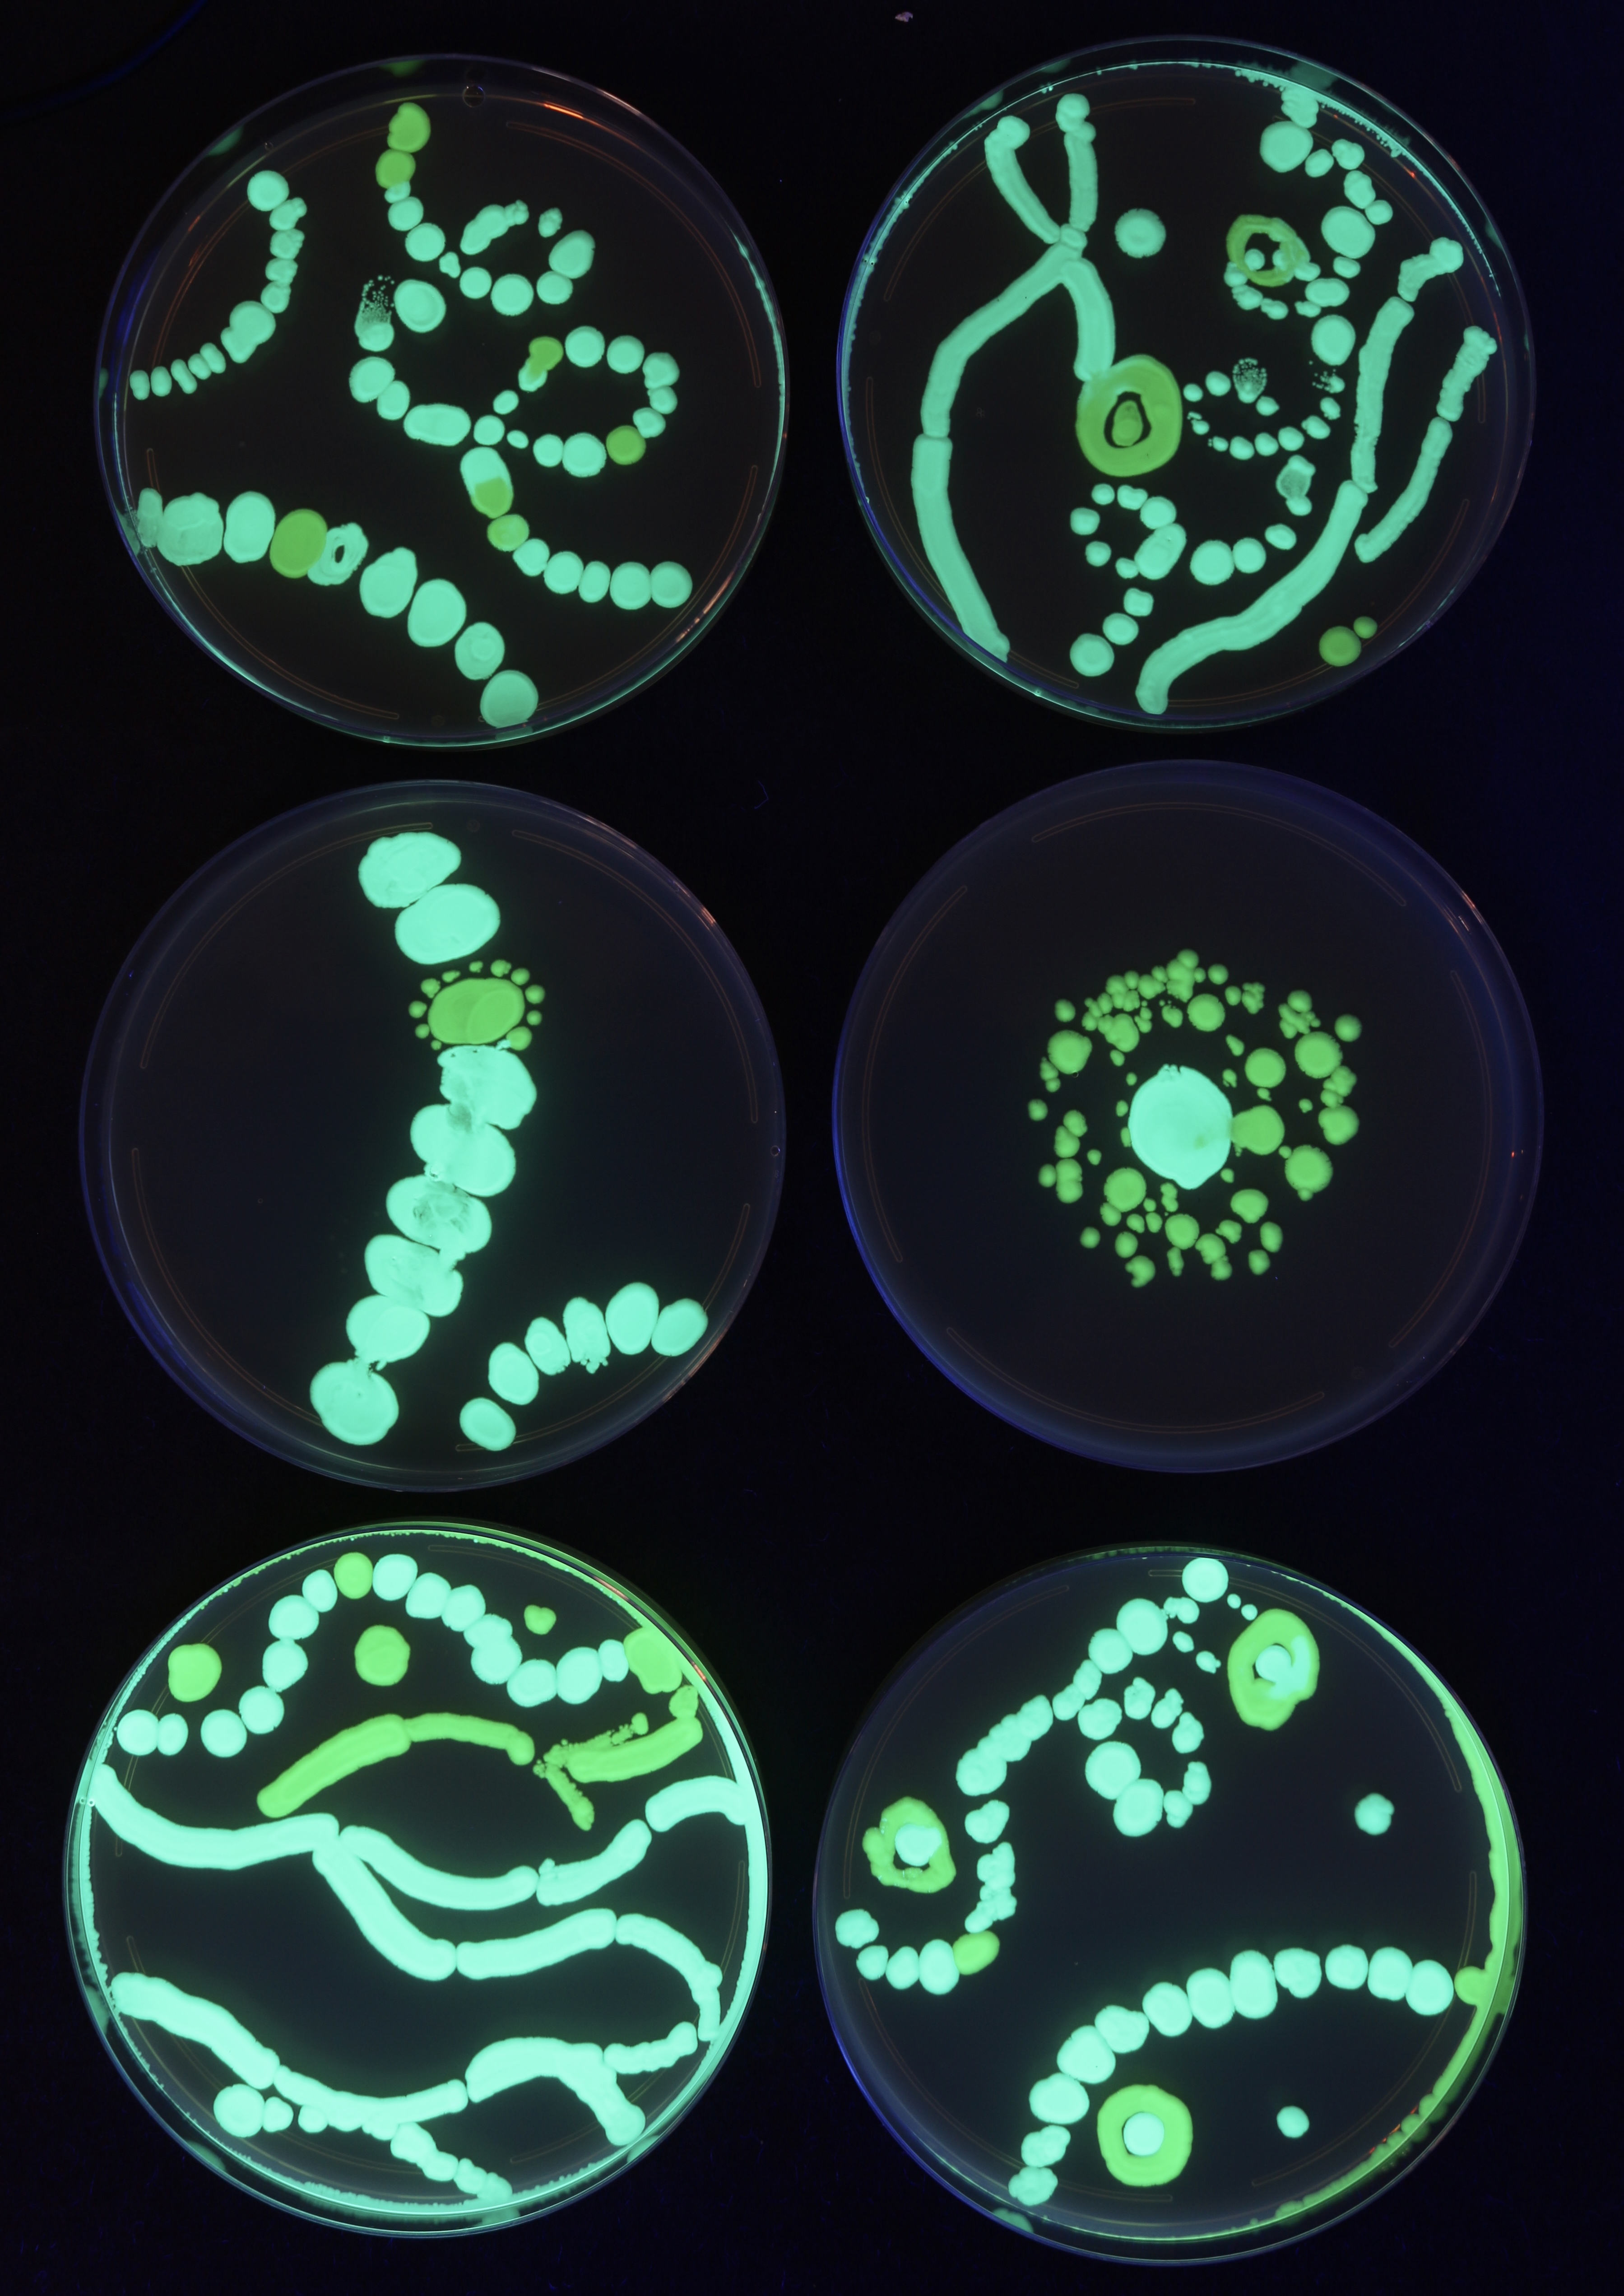

Bio Art, 2022
Summer 2022
One-month residency at SVA Bio Lab. I had the opportunity to experiment and play with many different materials, from fine art media, 3D printing to bio-materials such as bioluminescent bacteria printing and mycelium. The works culminated into an open-studio show “Ghost Ecologies: Hidden Kinships”. In the fall, part of my works were included in the “Darwin’s Paradox: A Decade of Bio Art” exhibition, at SVA Flatiron Gallery.